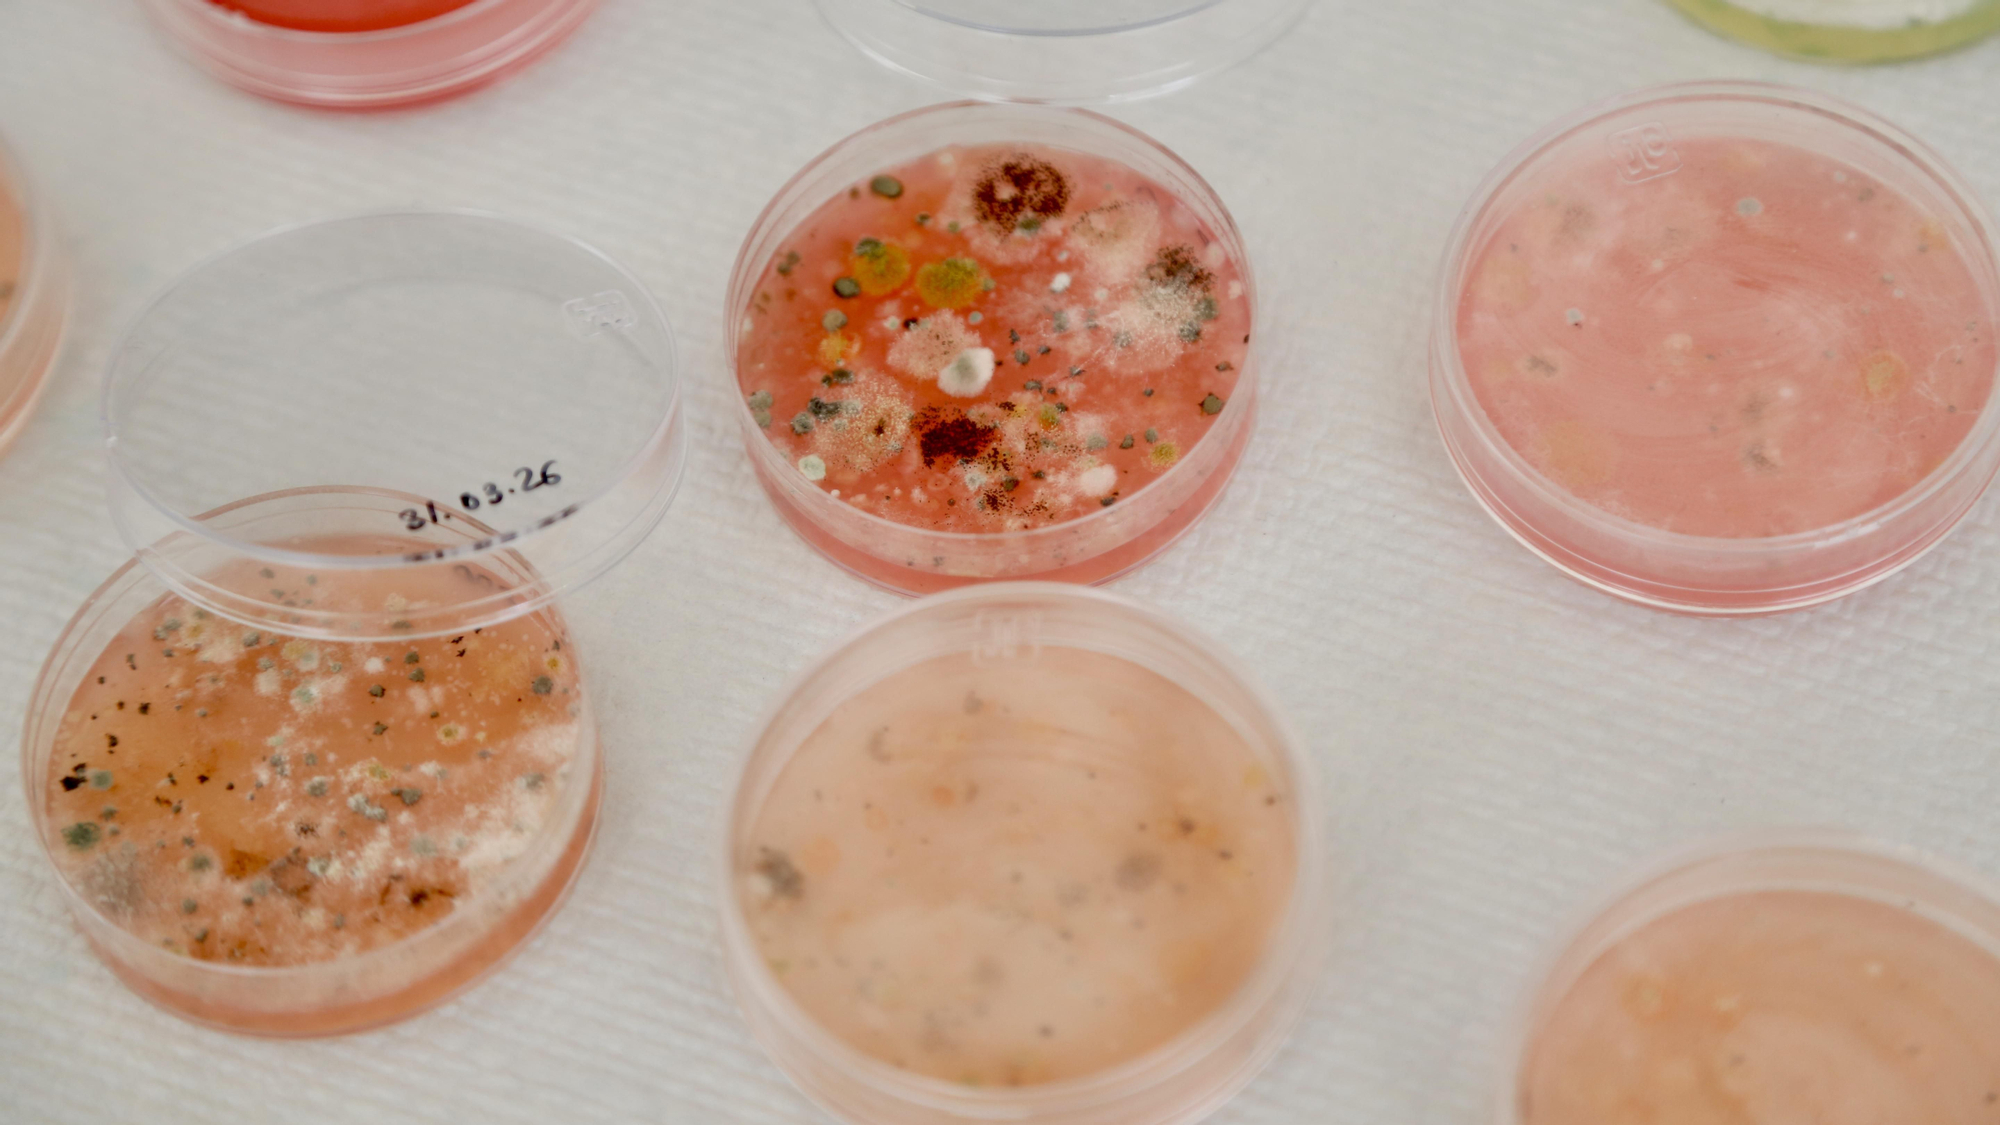
Paseo por la Ciencia 2026

Los laboratorios toman la calle para despertar las vocaciones de los futuros científicos
- El Vial acoge el Paseo por la Ciencia 2026 donde profesorado, investigadores y alumnado muestran ejemplos prácticos de la aplicación de las ciencias a la vida del día a día

Microscopios, probetas, pipetas, robots, bacterias y batas blancas inundan este sábado 11 de abril el paseo del Vial Norte con una nueva edición del Paseo por la Ciencia, el evento que cada año saca a la calle pequeños laboratorios para mostrar ejemplos prácticos de la aplicación de las ciencias a la vida del día a día y despertar las vocaciones de quienes serán los científicos del futuro.
“Descubre el micromundo que te rodea” o “Los reinos de los seres vivos” son algunos de los lemas que los centros participantes utilizan para atraer a los visitantes y contribuir a despertar esa mirada científica a nuestro alrededor en el día a día. Los participangtes han podido ver, por ejemplo, en la mesa de microorganismos cómo es el desarrollo de bacterias del yogur y cómo estos elementos tienen beneficios para la salud humana, o cómo se desarrollan hongos a partir de la suciedad que impregna nuestras manos si no las lavamos adecuadamente.
Los tipos de polen y el monitoraje aerobiológico para detectarlo, y las especies que producen más o menos alergias están de plena actualidad en esta primavera y, también sobre las plantas, experimentos sencillos muestran cómo la cubierta vegetal evita las escorrentías con las lluvias y que el suelo acabe siendo árido al perder la materia orgánica y sedimentos.
Los pequeños han podido interactuar en cada uno de los cuarenta expositores y ver, entre otras cosas, cómo construir unos pequeños robots a partir de piezas Lego y con los sencillos pasos de una aplicación hacer, por ejemplo, un mini robot aspirador que detecta obstáculos y cambia su rumbo, un 'perro' que responde a distintos estímulos o una cinta transportadora que distingue los objetos por colores para depositarlos en distintos contenedores.
Así, desde todo lo que rodea a los seres vivos y la naturaleza hasta la aplicación de la ciencia en la programación y construcción de herramientas, los visitantes del Paseo por la Ciencia han podido comprobar en primera persona cómo la ciencia está en todo lo que nos rodea y, para avanzar en el conocimiento, también debe avanzar la labor científica que, en un futuro, desarrollarán quienes ahora se acercan por primera vez a estos laboratorios en la calle.
Bajo el lema 'La ciencia siembra semillas que mejoran el futuro', esta edición del Paseo por la Ciencia ha contado con la participación de unas 1.100 personas de centros educativos de Primaria, Secundaria, Formación Profesional, distintas facultades de la Universidad y centros de investigación. El alumnado que ha asistido a la actividad procede de centros de la capital y la provincia de Córdoba, además de Ronda (Málaga) y Fuente de Cantos (Badajoz).
Paseo por la Ciencia 2026

Paseo por la Ciencia 2026
Paseo por la Ciencia 2026

Paseo por la Ciencia 2026
Paseo por la Ciencia 2026

Paseo por la Ciencia 2026
Paseo por la Ciencia 2026

Paseo por la Ciencia 2026
Paseo por la Ciencia 2026

Paseo por la Ciencia 2026
Paseo por la Ciencia 2026

Paseo por la Ciencia 2026
Paseo por la Ciencia 2026

Paseo por la Ciencia 2026
Paseo por la Ciencia 2026

Paseo por la Ciencia 2026
Paseo por la Ciencia 2026

Paseo por la Ciencia 2026
Paseo por la Ciencia 2026

Paseo por la Ciencia 2026
Paseo por la Ciencia 2026

Paseo por la Ciencia 2026
Paseo por la Ciencia 2026

Paseo por la Ciencia 2026
Paseo por la Ciencia 2026

Paseo por la Ciencia 2026
Paseo por la Ciencia 2026

Paseo por la Ciencia 2026
Paseo por la Ciencia 2026

Paseo por la Ciencia 2026
Paseo por la Ciencia 2026

Paseo por la Ciencia 2026
Paseo por la Ciencia 2026

Paseo por la Ciencia 2026
Paseo por la Ciencia 2026

Paseo por la Ciencia 2026
Paseo por la Ciencia 2026
Paseo por la Ciencia 2026
Paseo por la Ciencia 2026

Paseo por la Ciencia 2026
Paseo por la Ciencia 2026

Paseo por la Ciencia 2026
Paseo por la Ciencia 2026

Paseo por la Ciencia 2026
Paseo por la Ciencia 2026

Paseo por la Ciencia 2026
Paseo por la Ciencia 2026

Paseo por la Ciencia 2026
Paseo por la Ciencia 2026

Paseo por la Ciencia 2026
Paseo por la Ciencia 2026

Paseo por la Ciencia 2026
Paseo por la Ciencia 2026

Paseo por la Ciencia 2026
Paseo por la Ciencia 2026

Paseo por la Ciencia 2026
Paseo por la Ciencia 2026

Paseo por la Ciencia 2026
Paseo por la Ciencia 2026

Paseo por la Ciencia 2026
Paseo por la Ciencia 2026

Paseo por la Ciencia 2026
Paseo por la Ciencia 2026

Paseo por la Ciencia 2026
Paseo por la Ciencia 2026

Paseo por la Ciencia 2026
Paseo por la Ciencia 2026

Paseo por la Ciencia 2026
Paseo por la Ciencia 2026

Paseo por la Ciencia 2026
Paseo por la Ciencia 2026

Paseo por la Ciencia 2026
Paseo por la Ciencia 2026

Paseo por la Ciencia 2026
Paseo por la Ciencia 2026




0